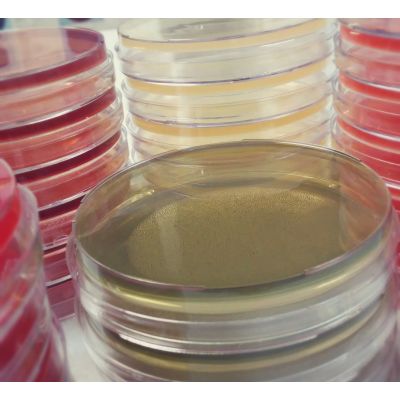
EMB AGAR

EMB AGAR
Fabricante:Cefar

Categorias:Microbiologia
Meio destinado ao isolamento e diferenciação de Enterobactérias, segundo a capacidade de fermentar a lactose e/ou sacarose.
APRESENTAÇÕES
Caixas com 10 frascos;
Caixas com 25 tubos;
Caixas com 10 placas.
Registro no MS: 101.106.200-63
TAG: Meios de cultivo
Resumo
Meio destinado ao isolamento e diferenciação de Enterobactérias, segundo a capacidade de fermentar a lactose e/ou sacarose.
APRESENTAÇÕES
Caixas com 10 frascos;
Caixas com 25 tubos;
Caixas com 10 placas.
Registro no MS: 101.106.200-63
TAG: Meios de cultivo
COMPARADOR
Adicione mais produtos
para comparar